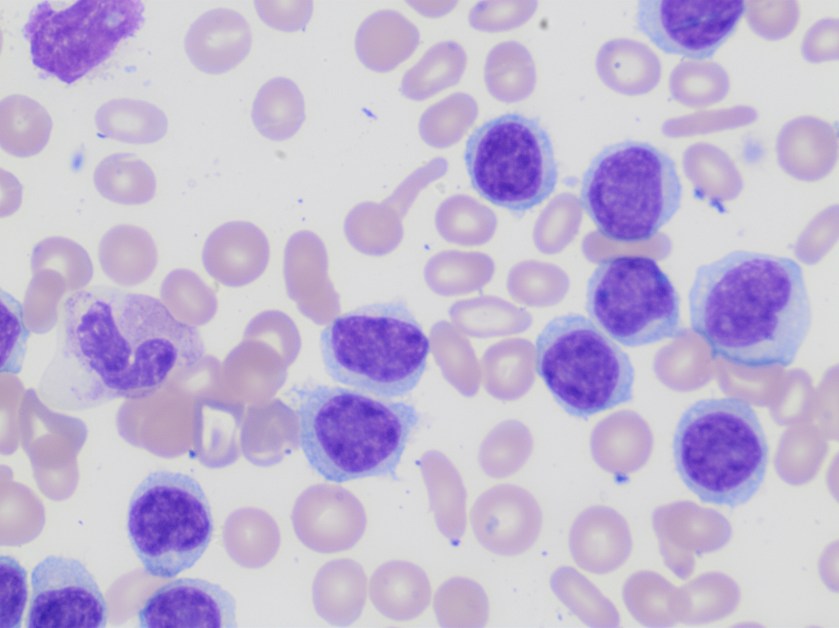
lymph1

Hello Lablogatory readers! We’d like to get to know you a little better and learn why you read this blog. Please take a few minutes to take this 4-question survey. Thank you for your input.
Category: Uncategorized
Lymphocytosis Can Be Anything
Case History
A 63 year old patient presented with a high white cell count of 108 K/uL and thrombocytopenia of 110 K/uL.
Peripheral smear examination revealed marked lymphocytosis with presence of numerous small to medium sized lymphoid cells with round to oval nuclei, clumped nuclear chromatin and variable amount of cytoplasm, some with cytoplasmic projections. As the features were consistent with a lymphoproliferative disorder peripheral blood was sent for flow cytometry.

Based on the morphology the differential diagnosis included B-cell lymphoproliferative disorders such as marginal zone lymphoma, hairy cell leukemia/variant, or less likely chronic lymphocytic leukemia and/or mantle cell lymphoma.
Flow cytometry revealed presence of clonal B-cells expressing CD19, CD20, Cd11c, CD103 and FMC-7. The cells were negative for CD5, CD10, and CD25.
The phenotype together with the morphology and CBC findings were diagnostic of hairy cell leukemia variant.
Discussion
Hairy cell leukemia variant ( HCL-v) is a B-cell lymphoproliferative disorder that resembles classic hairy cell leukemia but exhibits variant cytological and hematological features such as leukocytosis and also shows variant immunophenotype including absence of CD25, CD123 and/or annexin A1.
HCL-v is about one tenth as common as HCL (hairy cell leukemia) with an annual incidence of approximately 0.03 cases per 100,000 population. There is slight male preponderance. Patients with HCL-v typically present with leukocytosis with an average WBC of 30 K/ul and /or thrombocytopenia.
The 5 year survival rate is around 50-60%. Most patients require therapy which can range from splenectomy to combination chemotherapy with Rituximab.
Reference
- WHO classification of Tumors of Haematopoietic and Lymphoid Tissues; IARC 2017

Poll Friday: Thalassemia
Library Preparation – The First Step in a NGS Setup
Welcome back! Last quarter we discussed why Next Generation, or Massively Parallel, Sequencing is the next big thing in the world of Molecular Diagnostics. The sensitivity, the depth of coverage and the ability to interrogate many different areas of the genome at the same time were just a few of the benefits of these types of assays. Next, I would like to describe a couple different methods of library preparation, which is the first step necessary to run an NGS assay.
First of all, let’s define “Library.” I find this is the most common question technologists new to this technology ask. Essentially, a library is a specimen’s collection of amplicons produced by the assay that have been barcoded, tagged with appropriate platform adapters and purified. These will serve as the input for the next part of the NGS workflow, clonal amplification (the topic of next quarter’s blog!). How these libraries are prepared differ depending on platform (i.e, Ion Torrent vs. MiSeq), starting material (RNA vs. DNA), and type of assay (targeted amplicon vs. exome).
Before we begin the library prep discussion, a note about the input specimen. The DNA must be quantitated using a method that is more specific than spectrophotometry – it must be specific for double-stranded DNA. It will lead to an overestimation of the amount of DNA in the specimen, which will lead to over-dilution and consequently, lower quantity of final library. Real-time PCR and a double-stranded kit with fluorometry are two examples of assays that will give accurate concentrations of double-stranded DNA.
Our lab has begun using NGS for some of our oncology assays, so I will focus on the two types we perform currently, but keep in mind, there are many other types of assays and platforms.

The assay we use for our Ion Torrent platform is a PCR amplicon based assay. The first step is to amplify up the 207 regions over 50 genes that contain hotspots areas for a number of different cancer types. This all occurs in one well for each specimen. Once those areas are amplified, the next step is to partially digest the primer sequences in order to prepare the ends of amplicons for the adapters necessary for the sequencing step. As shown in the figure above, two different combinations of adapters may be used. The top one, listed as the A adapter (red) and the P1 adapter (green), would be used if only one specimen was to be sequenced on the run. The A and P1 adapters provide universal priming sites so that every amplicon of every sample can be primed with the same primers, rather than having to use gene specific primers each time. The second possibility is listed below that, with the same P1 adapter (green) and a Barcode Adapter labeled X (red and blue) – it still contains the A adapter necessary for sequencing (red), but it also contains a short oligonucleotide sequence called a “barcode” (blue) that will be recognized during the analysis step based on the sequence. For example, Barcode 101’s sequence is CTAAGGTAAC – this will be assigned to specimen 1 in the run and all of the amplicons for that specimen will be tagged with this sequence. Specimen 2 will have the barcode 102 (TAAGGAGAAC) tag on all of its amplicons. During analysis, the barcodes will be identified and all of the reads with the 101 sequence will be binned together and all of the reads with the 102 sequence will be binned together. This allows many specimens to be run at the same time, thus increasing the efficiency of NGS even more. Lastly, the tagged amplicons are purified and normalized to the same concentration.

The assay we use for our MiSeq platform is a hybridization followed by PCR amplicon based assay. The first step is to hybridize probes to 568 regions over 54 genes that contain hotspots for a number of different cancer types. This occurs in one well for each specimen. Once the probes have hybridized, the unbound probes are washed away using a size selection filter plate. Next, the area between the probes is extended and ligated so that each of the 568 amplicons are created. These are then amplified in a PCR step using primers that are complimentary to a universal priming site on the probes, but also contain adapters plus the two indices required for paired end sequencing (the Ion Torrent platform utilizes single-end sequencing – this will be discussed in the sequencing portion in an upcoming blog!). As in the previous method, after PCR, these tagged amplicons are purified and normalized to the same concentration in preparation for the next step – clonal amplification.
Stay tuned for next quarter’s post – clonal amplification!

-Sharleen Rapp, BS, MB (ASCP)CM is a Molecular Diagnostics Coordinator in the Molecular Diagnostics Laboratory at Nebraska Medicine.
Friday Poll: Variable K+ Results
Here’s to Fresh STARTs: Sustainable Transitions And Reachable Targets
From the title, you might be able to tell that I’ve been busy on Lab Management University (LMU). Going through the online modules and lessons in the LMU certificate program I mentioned this past May, I’ve been able to hone several skills in interpersonal communication, resource management, and project leadership. (A worthwhile investment through ASCP which I highly recommend!) Another thing that’s kept me quite busy over the last two years has been Zika-virus and mosquito-related public health initiatives both inside and outside the laboratory. In a recent blog post, I discussed the correlation between measuring success in projects like these just as one would with common lab-centric goals. And, as a conclusion to that hard work, this will be my last directly-related Zika/public health post. Transitioning to the second half of medical school, I’ll be leaving behind a true grassroots project that not only reached countless people but has the promise to be sustainable after my departure from the island of Sint Maarten back to the states.
As with many times in life, I would say fresh starts are a welcome chance to reflect and grow upon things you might have learned or goals you might be closer to finishing. What has been made clear to me in my time working through classrooms, cases, exams, and projects is that the “jargon” we use as laboratorians is definitely worth its weight. It isn’t full of hollow charges for metrics and goals; it’s about real data and real solutions. Having the ability to apply my prior experiences in laboratory medicine throughout medical school—both inside and outside the classroom—has been an invaluable benefit. The general principles that guided my last blog post reflected simple goals (i.e. turnaround time compared with public health metrics) which utilize fundamental models of data collection, adjustment, and success. The essential model I described a few months ago is now a mainstay of a project that will continue to improve public health statistics slowly as time goes on.

The model as it stands now consists of clear steps to identify problems which require interventions, highlight gaps in current practice, data collection from literature exists currently, collaboration with partners in a community of trust, and continuing those partnerships as improvements are made incrementally over time. The model has been repeated and successfully modified for these last two years from on-campus blood testing with procedural write-ups and data evaluation, to teaching school-aged children about mosquito prevention, to partnering with local government officials and having your projects adopted into their portfolio, and visiting individuals in their homes to discuss health and prevention.
To keep it brief, I’ve had an amazing experience here being able to lead and contribute to a wonderful and impactful project such as this. It has become increasingly clearer to me throughout this work that the values and skills programs like LMU teach are directly parallel with successes in various clinical settings. From the bedside to the laboratory to public health in the field, the lessons of how to effectively engage people and solve problems are critical. My time in laboratories before medical school, the daily grind of classwork here, and the projects I’ve been able to write about have all given me the space to try these skills on real situations—and hopefully that will make me the best clinician I can be after medical school is completed. Check out my “highlight reel” of partnerships, workshops, and active management in Zika prevention below.
Be sure to check back here next time, I’ll be writing from my hometown as I’ll explore ASCP’s Annual Meeting in Chicago, IL this coming September and report back on why it’s important to network and stay involved with our great professional community. Thanks for reading!



–Constantine E. Kanakis MSc, MLS (ASCP)CM graduated from Loyola University Chicago with a BS in Molecular Biology and Bioethics and then Rush University with an MS in Medical Laboratory Science. He is currently a medical student at the American University of the Caribbean and actively involved with local public health.
Microbiology Case Study: A 7 Month Old Female with Fever and Seizure-Like Episodes
Case History
A 7 month old female presented to the emergency department (ED) due to fever and seizure-like episodes. Her mother reported the child had been persistently febrile for 5 days (Tmax 103.9°F) with rhinorrhea, fussiness and decreased oral intake. The patient experienced 3 seizure-like episodes on the day of admission, which the mother described as periods of “shaking” with eyes rolling back. The child was unresponsive during these episodes, which lasted 1 to 2 minutes each. The child had been taken to her pediatrician the day prior to presentation to the ED where she was given a shot of ceftriaxone for presumed otitis media. The child received a chest x-ray, influenza testing, and blood and urine cultures were collected. She also had a lumbar puncture performed and the cerebral spinal fluid (CSF) was sent for chemistries, bacterial culture and polymerase chain reaction (PCR) testing for meningitis/encephalitis pathogens. She was started on IV ceftriaxone.
Laboratory Testing
The child’s white blood cell count from peripheral blood was 7.1 TH/cm2 and chest x-ray, urinalysis and flu testing were unremarkable. The CSF was clear and colorless with 7 WBC/cm2, glucose of 57 mg/dL and protein of 21 mg/dL. The cytospin Gram stain identified no organisms. The meningitis/encephalitis panel detected the presence of human herpesvirus 6 (HHV-6).
Discussion
Human herpesvirus 6 is a member of the Herpesviridae family and was the sixth herpes virus identified. Structurally, HHV-6 possesses a double stranded DNA genome and is enveloped. Clinically, it is the etiologic agent of roseola infantum (exanthum subitum) in infants and toddlers. Primary infection occurs in early childhood and those infected can be asymptomatic or have a non-specific febrile illness while only the minority present with the characteristic red macular rash prominent on the trunk and extremities, lymphadenopathy and high fevers. HHV-6 is highly neurotropic and as such causes viral encephalitis with 5-15% of children experiencing febrile seizures as a result of this illness. HHV-6 is highly prevalent with a greater than ninety percent seropervalence rate. HHV-6 establishes latency in T lymphocytes and can reactivate & cause disease, especially in immunocompromised patients such as those recipients of stem cell or solid organ transplants.
Traditional laboratory methods of identification for HHV-6 were challenging as viral culture, while once the gold standard for active disease, is not practical for most labs and is no longer used in routine diagnostics. PCR from serum, plasma or CSF has become the preferred test as there are now FDA-cleared, commercial platforms that are easy to use, allow for rapid turnaround time and in the case of multiplex PCR panels, the ability to target multiple pathogens from one test. Serology, while helpful in the diagnosis of primary infections, may not be provide conclusive results in a timely manner and is of limited utility in reactivation. Other less commonly used methods include immunohistochemistry, in situ hybridization and electron microscopy.
The prognosis for patients infected with HHV-6 is generally good with self-limited illness not requiring treatment. Rarely, multi-organ involvement can occur and HHV-6 infection in immunosuppressed patients can be a major cause of morbidity and mortality. There is no antiviral therapy licensed for the treatment of reactivated disease in this setting, but approaches using ganciclovir and valganciclovir have been proposed.
In the case of our patient, her blood, urine and CSF cultures were negative and her antibiotics were stopped after cultures were no growth at 24 hours. She required no treatment other than supportive care with acetaminophen for fever control. Prior to discharge, she developed a fine rash on her face, the back of her neck and trunk that was characteristic of an HHV-6 rash. This case demonstrates the utility of multiplex PCR testing in providing rapid identification of pathogenic organisms allowing for real time diagnosis and the limiting of unnecessary treatment.

-Eric Tillotson, MD, is a second year Anatomic and Clinical Pathology resident at the University of Mississippi Medical Center.

-Lisa Stempak, MD, is an Assistant Professor of Pathology at the University of Mississippi Medical Center in Jackson, MS. She is certified by the American Board of Pathology in Anatomic and Clinical Pathology as well as Medical Microbiology. She is the director of the Microbiology and Serology Laboratories. Her interests include infectious disease histology, process and quality improvement and resident education.
Poll: Differentials on Patients with CLL
In a new paper on Lab Medicine, Gulati et al discuss counting smudge cells as lymphocytes on patients with confirmed or suspected chronic lymphocytic leukemia. Check out the paper and take our poll.
Urine Luck: The Diagnostic Value of Urine Dipstick Testing
A major challenge to providing diagnostic laboratory services in resource-limited settings, like the refugee camps discussed in last month’s post, is lack of infrastructure. Without running water, electricity, and even access to good phlebotomy supplies, specimen collection and preparation can be difficult, let alone the actual testing. I’ve found that in many instances, going back to the basics can often help determine a means of providing useful laboratory results. This post focuses on the humble, yet powerful, urine dipstick.
The urine dipstick is lightweight, easily portable, requires no special handling or storage and most have long shelf lives. These characteristics make the dipstick a great tool for use in the field. The specimen–simply urine–is also easy to collect and requires no special preparation. Dipstick testing can serve as a screening tool for some diseases and a diagnostic test for others. Urine dipstick measures pH, specific gravity, nitrites, leukocyte esterase, peroxidase activity, glucose, ketone, bilirubin, protein, and urobilinogen all performed within about a minute.
Urine is slightly acidic fluid and its pH is maintained essentially by the kidney. Any acid-base imbalance affects urinary pH. Urinary pH levels are helpful in the evaluation of nephrolithiasis, infection, and renal tubular acidosis. Kidney’s ability to concentrate urine is readily assessed by measuring the specific gravity of urine and the measurement generally correlates with urine osmolality.
Both nitrites and leukocyte esterase are used to evaluate urinary tract infection (UTI). A specific group of bacteria with reductase enzyme reduces nutritional nitrates in urine to nitrites which is detectable by urine dipstick testing. Some bacteria are not capable of converting nitrates to nitrites and therefore patients with UTI could still be negative for nitrite. Patients on a nitrate-deficient diet could be negative for nitrite despite the presence of bacteria with reductase enzyme in urine. In addition, the conversion of nitrate to nitrite requires time as well as at least 10,000 bacteria in milliliter of urine for the chemical reaction on the pad to occur. Thus, first morning urine is a specimen of choice for nitrite test. Outdated dipstick or a dipstick exposed to air could also cause a false positive reaction for nitrite. In the context of these limitations, nitrite test is only specific (92-100%) for bacteria capable of converting nitrate to nitrates and has very poor sensitivity (19-48%).
Leukocyte esterase is an enzyme produced by neutrophils. This enzyme is released from lysed neutrophils. The presence of esterase enzyme in the urine may imply UTI. However, white blood cells could present in the urine secondary to bacterial and viral infections, or because of other conditions such as tumor in the bladder. Unlike nitrite, leukocyte esterase is somewhat sensitive (72-97%) but not as specific (41-86%).
The presence of glucose or ketone in the urine is not normal. Glucose is detected in the urine when the blood glucose level is greater or equal to 180 mg/dL. In this level of glucose in blood, the kidney readily overwhelms its ability to re-absorb by filtering excess glucose. The presence of ketone in urine is suggestive of poorly managed blood glucose level, starvation, and prolonged fasting. When used combined, both measurements can be used to identify and monitor diabetic patients.
Detectable protein (only detects albumin, not other proteins) in urine is indicative of renal disease. The normal protein level in urine is less than 150 mg/dL and is below the threshold a urine dipstick can detect. Significant proteinuria with 96% sensitivity and 87% specificity is detected when urine protein level exceeds 300 mg/dL. Because of its insensitivity to microalbuminuria, dipstick test has limited clinical utility in screening diabetic patients.
Urine dipstick is used to identify the peroxidase activity of red blood cells, not for the presence of intact erythrocytes. Therefore, urine dipstick alone cannot be used to diagnose hematuria unless combined with microscopy finding. Hematuria is defined by American Urological Association the presence of at least 3 red blood cells per high power field. Positive peroxidase activity in the absence of red blood cells under microscope could mean myoglobinuria (e.g. caused by rhabdomyolysis), hemoglobinuria (e.g. caused by hemolytic condition and infections), or false positives. False-positives could arise from urine contamination with oxidizing agents, semen in the urine, blood contamination from hemorrhoids or vaginal bleeding, or from foods and medications such as beets, hydroxocobalamin, and phenazopyridine.
The presence of detectable conjugated bilirubin and/or urobilinogen is suggestive of liver disease, in vivo hemolysis, and/or biliary obstruction. Low concentration of urobilinogen in urine is normal. Bilirubin is converted to urobilinogen by bacteria in the intestine.
The chemical analysis of urine provides valuable information about the function of multiple organs or systems within a very short analytical time. If the limitations and inferences of the chemical reactions are properly addressed during interpretation, the diagnostic utility of urine chemical test is high. In situations where access to laboratory testing is low, the dipstick can provide clues to aid diagnosis.
-Merih Tewelde, PhD, contributed to this post.

–Sarah Riley, PhD, DABCC, is an Assistant Professor of Pediatrics and Pathology and Immunology at Washington University in St. Louis School of Medicine. She is passionate about bringing the lab out of the basement and into the forefront of global health.
ASCP 2017: Calling All Abstracts
